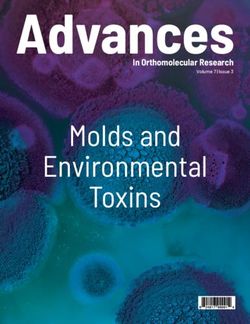
Advances Molds and Environmental Toxins - In Orthomolecular Research

A Performer's Guide to Concierto de Otoño (Autumn Concerto) for Trumpet and Orchestra by Arturo Márquez
←
→
Page content transcription
If your browser does not render page correctly, please read the page content below
Please do not remove this page A Performer's Guide to Concierto de Otoño (Autumn Concerto) for Trumpet and Orchestra by Arturo Márquez Montes Valencia, Federico https://scholarship.miami.edu/discovery/delivery/01UOML_INST:ResearchRepository/12380829970002976?l#13380819900002976 Montes Valencia, F. (2021). A Performer’s Guide to Concierto de Otoño (Autumn Concerto) for Trumpet and Orchestra by Arturo Márquez [University of Miami]. https://scholarship.miami.edu/discovery/fulldisplay/alma991031581689802976/01UOML_INST:ResearchR epository Open Downloaded On 2021/08/03 02:28:28 -0400 Please do not remove this page
ii
UNIVERSITY OF MIAMI
A PERFORMER’S GUIDE TO CONCIERTO DE OTOÑO (AUTUMN CONCERTO)
FOR TRUMPET AND ORCHESTRA BY ARTURO MÁRQUEZ
By
Federico Montes Valencia
A LECTURE RECITAL ESSAY
Submitted to the Faculty
of the University of Miami
in partial fulfillment of the requirements for
the degree of Doctoral of Musical Arts
Coral Gables, Florida
May 2021
iiUNIVERSITY OF MIAMI
A lecture recital essay submitted in partial fulfillment of
the requirements for the degree of
Doctor of Musical Arts
A PERFORMER’S GUIDE TO CONCIERTO DE OTOÑO (AUTUMN CONCERTO)
FOR TRUMPET AND ORCHESTRA BY ARTURO MÁRQUEZ
Federico Montes Valencia
Approved:
____________________________ ____________________________
Craig Morris, M.M. Margaret Ann Donaghue, D.M.A.
Associate Professor of Instrumental Associate Professor of Instrumental
Performance Performance
____________________________ ____________________________
Aaron Tindall, D.M.A. Guillermo J Prado, Ph.D.
Associate Professor of Instrumental Dean of the Graduate School
Performance
____________________________
Reynaldo Sanchez M.M.
Professor of Music Business and
Entertainment Industries
Performanceii
MONTES VALENCIA, FEDERICO (D.M.A., Instrumental Performance)
(May 2021)
A Performer’s Guide to Concierto de Otoño (Autumn Concerto) For Trumpet and
Orchestra by Arturo Márquez
Abstract of a dissertation at the University of Miami.
Lecture Recital essay supervised by Professor Craig Morris.
No. of pages in text. (51)
In recent times, there has been a need for the expansion of the trumpet repertory as
a solo instrument, especially in works by Latin American composers. Based on experience,
some of the most performed trumpet concertos are not from any composers south of the
United States border connecting with Mexico. This paper focuses on the work of Mexican
composer, Arturo Marquez, who showcases the colors of the trumpet as a solo instrument
in his Concierto de Otoño (Autumn Concerto), written in 2018.
This essay will provide: Biographies on Arturo Márquez and Francisco Flores
(trumpeter who premiered the piece), an overview of the concerto, pedagogical ideas for
those wanting to learn the piece, and information about the commissioning process. This
includes the experiences of the parties involved in the process during the time while
composing the piece and also what went on in making the project a reality. This paper will
also include a brief musical/theorical analysis of each one of the movements in the
concerto, as well as information about suggested equipment for each piece; including the
review of the possibilities for performing these concertos without having to purchase new
instruments.
iiiii
Table of Contents
LIST OF EXAMPLES .......................................................................................................iv
LIST OF TABLES..............................................................................................................vi
Chapters
1. ARTURO MÁRQUEZ BIOGRAPHY………...………………………………….1
2. CONCIERTO DE OTOÑO ……………………………………...………………...4
SON DE LUZ (DANCE OF LIGHT)………………………………………8
EQUIPMENT NOTES……………………………………...……12
PEDAGOGICAL NOTES ………………………………………14
BALADA DE FLORIPONDIOS (BALLADE OF FLORIPONDIOS ……16
EQUIPMENT NOTES…………………………………………...19
PEDAGOGICAL NOTES .………………...…………………….20
CONGA DE FLORES (CONGA OF FLOWERS) ……………………….22
EQUIPMENT NOTES…………………………………………...29
PEDAGOGICAL NOTES………………..……………………...30
3. FRANCISCO “PACHO” FLORES BIOGRAPHY……………………………...34
4. CONCLUSION ……………………………………………………………….....37
Bibliography……………………………………………………………………………..38
Appendix A: Copyright Watermark on Score with Using Rights for this Document……40
Appendix B: Keynote Presentation Slides for Lecture Recital…………………………..41
iiiiv
List of Examples
Page
Example 1: Score Measure 4………………………………………………………..........9
Example 2: A Theme on Strings Measure 19…….……………………………………...10
Example 3: B Section Strings and Trumpet Measure 31……...…………………………11
Example 4: A’ Section and Syncopation on Strings Measure 209 ……………………….12
Example 5: Lowest Note in First Movement in Measure 164………………..…………...13
Example 6: Highest Note in First Movement in Measure 235……………………………13
Example 7: Syncopation Exercises No. 1………………………………………………...15
Example 8: Syncopation Exercise No. 2…………………………………………………15
Example 9: Flower of Floripondio………………………………………………………..16
Example 10: Treble Clef in Solo Line…………………………………………………….17
Example 11: First Variation on Cornet…………………………………………………...18
Example 12: Second Variation on Cornet………………………………………………...19
Example 13: Double Tonging Exercises………………………………………………….22
Example 14: Conga de Flores Theme Measure 4…………………………………………23
Example 15: Theme on Strings Measure 21……………………………………………...23
Example 16: First Episode (4 Measures)…………………………………………………24
Example 17: First Episode (2 Measures)…………………………………………………25
Example 18: First Episode (1 Measure)…………………………………………………..25
Example 19: Second Episode………….…………………………………………………26
Example 20: Second Episode on Strings…………………………………………………27
ivv
Example 21: Conga Introduces Third Episode…………………………………………...27
Example 22: Third Episode on Trumpet………………………………………………….27
Example 23: Combination of First and Third Episode…………………………………...28
Example 24: Final Glissando and End of Piece Measure 303…………………………….29
Example 25: Recommended Agility Clarke Exercises…………………………………...31
Example 26: Recommended Arban Agility Exercise No. 1………………………………32
Example 27: Recommended Arban Agility Exercise No. 2………………………………33
vvi
List of Tables
Page
Table 1: Instrumentation of Concierto de Otoño by Movements………………………… 5
Table 2: Schedule for Premiere of Concierto de Otoño………………………………….. 6
Table 3: Concert Program for Concierto de Otoño by Orquesta Filarmónica de Bogotá…7
vi1
Chapter 1
Arturo Márquez Biography
Arturo Márquez was born on December 1950 in Alamos, Sonora, Mexico. Son of
Arturo Márquez from Arizona (USA) and Aurora Navarro from Sonora (Mexico). His
father was his first musical influence being a violinist and mariachi player as well as a
carpenter, a father who was member of a quartet comprised of himself on the violin, his
grandfather on the guitar, his aunt on the flute, and his uncle on the double bass. Arturo
Márquez’s first musical experiences were listening to this quartet perform pieces in
rhythms such as waltz, polkas, and traditional folk songs of Mexico, as well as small bands
from Sinaloa performing at the end of the year festivities.1 Out of his nine siblings he is the
eldest and the only one who has dedicated his life to music.
He began his classical music training in La Puente, California in 1966, in violin,
tuba, and trombone; later studying piano and music theory at the Conservatory of Music in
Mexico and composition at the Taller de Composición (Composition Workshop) of the
Institute of Fine Arts of Mexico with composers such as Joaquín Gutiérrez Heras, Hector
Quintanar, and Federico Ibarra. He also studied in Paris privately as a scholarship holder
by the French government with Jacques Castérède, and at the California Institute of the
Arts (CalArts) with Morton Subotnick, Stephen Mosko, Mel Powell, and James Newton.2
1
Marquez, Arturo “Amante de La Musica Mariachi Del Parrandon Vallenato,” Arturo Marquez “El Gran
Compositor,” October 13, 2019, http://www.arturomarquez.org.
2
Marquez
12
By then Márquez had already written a few pieces such as Moyolhuica and Enigma.
After studying at CalArts Márquez began including in his compositions a mix of jazz, Latin
music, and contemporary music.
In 1992 Márquez composed Son a Tamayo for harp, percussion and tape, which
was featured at the 1996 World Harp Congress. In 1994 the National Autonomous
University of Mexico's Philharmonic Orchestra, which is now the eldest symphonic group
in Mexico3 commissioned his famous Danzon 2, which is among the most popular Latin
American works to emerge since that year, inspired by Cuban elegant dances that were
adopted by people in Veracruz, Mexico.
After his Danzon 2 he composed pieces such as Danzón 3 (1994), Zarabandeo
(1995), Danzón 4 (1996), Octeto Malandro (1996), Danza de Mediodía (1996), Danzón 5-
Portales de Madrugada (1997), Danzón 6 (2001), Danzón 7 (2001) y el Danzón 8 (2004).
In the 2000s he was commissioned by known orchestras and conductors such as
Carlos Miguel Prieto (fellow Mexican conductor of Louisiana Philharmonic Orchestra,
Mexican National Symphony as well as the Youth Orchestra of Americas4) pieces like
Espejos en la Arena (Mirrors in the Sand) for cello and orchestra, a piece which a few years
after was adapted for viola and orchestra and premiered in Italy by Ines Salaks. 5
In February 2006, Márquez received the “Medalla de Oro de Bellas Artes” (Gold
Medal of Fine Arts), the highest honor given to artists by Mexico’s Bellas Artes. That
3
Eduardo Bárzana García, “Orquesta Filarmónica de La UNAM,” www.amigosofunam.unam.mx, accessed
November 12, 2020, http://www.amigosofunam.unam.mx.
4
Carlos Miguel Prieto, “Carlos Miguel Prieto,” www.carlosmiguelprieto.com, accessed November 12,
2020, http://www.carlosmiguelprieto.com/en/.
5
Márquez
23
evening the concert “El Danzon según Márquez” (The Danzón according to Márquez) was
presented at the Palacio de Bellas Artes.6
6
Orchestra Americas, “Arturo Márquez – The Orchestra of the Americas,” Orchestra of the Americas,
March 23, 2006, http://oamericas.org/people/arturo-marquez-2/
34
Chapter 2
Concerto de Otoño
Concierto de Otoño (Autumn Concerto) for trumpet and orchestra comes as part of
Venezuelan trumpeter Francisco Flores’s idea to commission different pieces for the
trumpet, looking to expand the repertory written of the instrument. In his project of
compositions, he has already included pieces by Grammy Award nominee Puerto Rican
composer Roberto Sierra, Cuban composer and Clarinetist Paquito D’Rivera, Uruguayan
composer and flutist Efrain Oscher, and Swedish composer and international trombone
soloist Christian Lindberg. Autumn Concerto was commissioned jointly by four orchestras
in different parts of the world, Orchestra Sinfónica Nacional de México (Mexico National
Symphony), Tucson Symphony Orchestra in USA, Hyogo PAC Orchestra in Japan, plus
the Oviedo Filarmonia in Spain and it marks Arturo Márquez’s latest published work by
Particella Ediciones in Spain. The piece was premiered by the Orquesta Sinfónica Nacional
de México at Palacio de Bellas Artes, Mexico on September 9th of 2018, conducted by
Carlos Miguel Prieto and Francisco “Pacho” Flores in the trumpet.
The piece itself is 16 minutes long and was composed between January and June
of 2018. It has three movements: Son de luz, Balada de Floripondios and Conga de Flores
and it highlights a colorful number of instruments in the accompanying orchestra and four
different kinds of trumpets throughout the concerto for the soloist.7
7
Stomvi Trumpets, “Pacho Flores Premieres Arturo Márquez’s Trumpet Concerto | Pacho Flores,”
pachoflores.com, accessed November 12, 2020, https://pachoflores.com/en/news-en/pacho-flores-
premieres-arturo-marquezs-trumpet-concerto.
45
Francisco “Pacho” Flores is an artist of the Spanish instrument manufacturer
Stomvi. Thanks to his involvement with the development of each one of the instruments,
he has access to a wide range of options to choose from when deciding on what he believes
is more appropriate for the pieces he commissions, arranges or composes. This range of
options is much greater than most trumpet players have at their disposal.
To have an idea of these differences, a relatively small set of instruments could
range between Bb trumpet, C trumpet, and four-valved A/Bb piccolo in a trumpeter’s case
versus a vast set which might include Bb trumpet, C piston and C rotary trumpet, D/Eb
trumpet, four-valved A/Bb piccolo, Bb cornet, C cornet, and flugelhorn. Meanwhile
Pacho’s might include but not being limited to Bb trumpet, C trumpet, D/Eb trumpet, F/G
trumpet, A/Bb piccolo, C piccolo, Bb cornet, C cornet, Eb cornet, F soprano cornet,
flugelhorn, and corno da caccia. Also, the understanding that all of his instruments with
the exception of the corno da caccia being extended range four-valved instruments.
Table 1: Instrumentation of Concierto de Otoño by Movements
1. Son de Luz (Dance of Light)
2[1.2/picc] 2 2 2 – 4 2 3 1 – tmp+4 C Trumpet, str
2. Balada de Floripondios (Balade of Floripondio)
2[1.2/picc] 2 2 2 – 4 2 3 1 – tmp+4 Bb Flugelhorn F Soprano Cornet, str
56
3. Conga de Flores (Conga of Flowers)
2[1.2/picc] 2 2 2 – 4 2 3 1 – tmp+3 D Trumpet, str
The schedule of the four premiers was planned as follows:
Table 2: Schedule for Premiere of Concierto de Otoño
Date Orchestra Conductor Place
September 7th, 8th, 9th of National Symphony Carlos Miguel Prieto Palacio de Bellas Artes,
2018 Orchestra of Mexico Mexico DF.
January 25th, 27th of Tucson Symphony Jose Luis Gomez Tucson Music Hall
2019 Orchestra
May 24th, 25th, 26th, of Hyogo PAC Orchestra Michiyoshi Inoue Hyogo Performing Arts
2019 Japan Center
th
August 14 of 2019 Oviedo Filarmonia Lucas Macías Auditorio Príncipe
Spain Felipe
Concerto de Otoño has attracted the interest of many orchestras and has already
been scheduled for the 2019/20 and 2020/21 seasons in the United States, Colombia, Spain,
France, England, Canada and Australia, adding up to 30 performances in only its first three
years. These include the Opening Night Gala of the Louisiana Philharmonic Orchestra,
with Carlos Miguel Prieto; Orquesta Filarmónica de Bogotá (Colombian premiere),
Christian Vásquez; Colorado Springs Philharmonic, Josep Caballé Doménech; Real
Filharmonía de Galicia, with Manuel Hernández-Silva. Many of these events
unfortunately, did not happen due to the Covid-19 pandemic.8
8
Magan, Carlos. “ACM Concerts, Autor En ACM Concerts - Page 5 of 11.” ACM Concerts. ACM Concerts.
Accessed March 1, 2021. https://acmconcerts.com/en/author/carlos-magan/page/5/.
67
Table 3: Concert Program for Concierto de Otoño by Orquesta Filarmónica de Bogotá
9
Some notes in the third page of the score from the composer originally written in
Spanish translate to “The trumpet is the queen in Mexico’s soul; we will practically find
her in all the popular musical expressions, it is Mexico’s voice of happiness and sadness.
It also is fundamental in Latin American concert music and my Autumn Concerto is a
recompilation of all those feelings, smells, and comforts.”10
9
Orquesta Filarmónica de Bogotá, and Orquestafilarmonicadebogota. “Programa De Mano Octubre y
Noviembre 2019 Orquesta Filarmónica De Bogotá.” Issuu, October 1, 2019.
https://issuu.com/orquestafilarmonicadebogota/docs/programa_de_mano_octubre_-_noviembre.
10
Marquez, Arturo. Concierto De Otoño Para Trompeta y Orquesta. Valencia: Particella Ediciones, 2018.
78
The examples provided from the score in the next sections of this document have
been approved by Particella Ediciones (Spain), the editorial for Concierto de Otoño
(Appendix). Copyright © 2019. Particella Ediciones, SL. Valencia (Spain).
Son de Luz (Dance of Light)
The first movement of the concerto is inspired by the acquaintance with new
horizons of peace and reconciliation. With a Mestizo rhythm it shows a dialogue between
the trumpet and the orchestra in a classic sonata form. 11
The A section of this sonata form concerto is found between measures 1 and 30.
The D minor chord presented in this introduction of the orchestra with a unison figure of
dotted-eighth, sixteenth and eighth note followed by a quarter note and an eighth note rest
in rhythm of 6/8, joined by the trumpet with a double forte dynamic and heroic-like line on
measure 4 (Example 1).
11
Marquez
89
Example 1: Measures 4 – 8
The first melodic motive shown on Example 3 lasts until measure 19 in the trumpet
with an immediate response by the string section with the same thematic music, showing
the composers intention for it to be a dialog between soloist and orchestra (Example 4).
910
Example 2: A Section Theme on Strings Measure 1
//
1011
The first thematic music continues until measure 30 where the trumpet introduces
the B section with a very rhythmic syncopated theme and directly alternating the musical
dialogue with the strings and some members of the woodwind section as well (Example 5).
Example 3: B Section Strings and Trumpet Measure 31
The recapitulation of the piece has the same thematic material as the beginning, but
includes longer phrases on the melody line, harmonic support by all brass instruments and
syncopation underneath using the material from the B section in all woodwinds, some
strings and some percussion, resulting in an A’ section (Example 8). The movement also
ends on a D minor, keeping it consistent with the same key as the A section.
1112
Example 4: A’ Section and Syncopation on Strings Measure 209
Equipment Notes
The movement is written for C trumpet, which is a very common instrument.
Although Francisco “Pacho” Flores played a Stomvi Titán C four-valve edition trumpet,
the main purpose of the fourth piston added in the trumpet is to allow the player to play
five semitones below the standard range of the instrument in any key. The lowest note
playable naturally without the help of the pedal notes on a standard C trumpet is a F#3; on
a Stomvi Titán C four-valve or any other four-valved C trumpet edition it would be a Db3.
The first movement can be played with any standard three piston or rotary C
trumpet. The lowest note in the movement is a G3 (Example 9) and its highest is a D6
(Example 10) which does not require you to buy a four-valve edition trumpet. Depending
on the performer it could be preferred to play the highest note at the end of the first
movement (D6) on a slightly higher keyed instrument such as an Eb trumpet but given the
fact that there are 238 measures in the first movement and the solo trumpet plays about
81% of it, it is not recommended to switch instruments within the movement itself.
1213
Example 5: Lowest Note in First Movement in Measure 164
Example 6: Highest Note in First Movement in Measure 235
1314
Pedagogical Notes
Practice suggestions include practicing the appropriated breathing for the beginning
of this phrase, a deep and yet powerful breath that will allow them to play the double forte
(ff) marked in the solo part. One of the big challenges of this concerto will most likely be
endurance of the soloist, for that reason good breathing and good technique are key. The
sixteenth notes in measures 6-9 and each one of the repeating looking-like lines should be
very fluid, but the articulations should be very crisp putting special attention to the
accidentals presented before the beginning of a new phrase.
Syncopation is not something every musician is comfortable with or maybe even
used to. The geography of where one grew up might have an influence as well as the kind
of multi-cultural experiences one has had in the length of the musical career. As a
recommendation for those who wish to improve in syncopation and have a more natural
feeling when playing this section of the first movement, the Arbans Complete Celebrated
Method for the Cornet by Edwin Franko Goldman studies of syncopation are suggested,
located on page 23 of the book (Example 6) a download link to the public domain version
used in this essay is available in footnote 12 as well as the bibliography of this document.
Also, using a metronome with a quarter note equaling 210 beats per minute, try playing the
figures shown in Example 7 but replacing the notes with only a G3 in a C trumpet and
gradually adding the notes shown in the solo part.
1415
Example 7: Syncopation Exercises No. 1
12
Example 8: Syncopation Exercise No. 2
12
Goldman, Edwin Franko. Arbans Complete Celebrated Method for the Cornet. New York: Carl Fischer,
1893. Plate 3654. Copyright Public Domain.
https://imslp.org/wiki/Method_for_the_Cornet_(Arban%2C_Jean-Baptiste)
1516
Balada de Floripondios (Ballade of Floripondios)
This movement has been written for a Bb four-valved flugelhorn and a F Soprano
four-valved cornet. It is inspired by the flower called Floripondio because of its trumpet
bell like shape and its properties, described by Merriam Webster dictionary as,
“any of several tropical American shrubs or trees of the genus Datura (especially
D. candida) that have narcotic seeds from which an intoxicant is prepared and that
are sometimes cultivated in warm regions especially for their very large commonly
white flowers”13
Example 9: Flower of Floripondio
14
13
Merriam-Webster.com Dictionary, s.v. “floripondio,” accessed March 11, 2021, https://www.merriam-
webster.com/dictionary/floripondio.
14
“Predeterminado Del Sitio.” Info del NEA, August 11, 2020.
https://infodelnea.com.ar/wp/2020/08/11/las-plantas-venenosas-a-tener-cuidado/.
1617
For this movement the composer chose a Chaconne form creating a theme and
variations. It starts with a dark sounding flugelhorn line in the key of G minor for the first
69 measures and continuing with the cornet until the end of the movement. Something very
special about the writing for the flugelhorn part is that in the score it is in bass clef rather
than treble clef, which is what trumpet players are most accustomed to reading (Example
10). The change of clef is due to the low register able to be achieved by the fourth piston
in the instrument as explained in page 9 of this document.
Example 10: Treble Clef in Solo Line
Utilizing the extended low register of the four-valve flugel horn in the opening of
the 2nd movement gives it the very mysterious and hallucinogenic sense that the
Floripondio plant would. It feels almost like a slow Danzón when accompanied by the
maracas.
On measure 75 when the cornet is introduced, the score changes to treble clef as it
would have been expected from the beginning. The instrument used for the premier was a
Stomvi Titán F 4 valve edition Cornet and it exposes a new musical line that almost acts
1718
as an accompaniment to the firsts violins and the violas playing the melody once introduced
by the flugelhorn at the beginning of the movement (Example 11). The cornet line repeats
twelve times with small adjustments but maintains the same articulations as in measure 79
(Example 11).
Example 11: First Variation on Cornet
Between measures 97 and 112 maestro Márquez introduces Variation 2 (Example
12) in the solo part that will most likely require the performer to use double tonging
technique, yet again Márquez accompanies the new thematic music in the solo part with a
previously heard melody but in the first violins, violas, flutes and clarinets.
1819
Example 12: Second Variation on Cornet
Equipment Notes
In Balada de Floripondios it is necessary to have the four-valved flugelhorn to be
able to accomplish what the composer wrote in the solo part.
Francisco “Pacho” Flores uses a Stomvi Titán Bb 4 valve edition Flugelhorn for
the premiere of the concerto. I have learned through emailing the Stomvi distributors in the
United States that all four-valved instruments are a “special request” which means they
will only bring it from Spain for someone that has already agreed to purchase the
instrument rather than having them on hand for people to try.
The opening of this movement, with its tessitura consistently lying outside the range
of the standard 3-valve flugelhorn, requires the use of a 4-valve instrument. However, from
measure 75 to the end of the movement, written for a 4-valve F soprano cornet, could be
played on an Eb cornet instead. It would provide no limitations and offer an almost identical
sound quality to the much less commonly found F soprano cornet. Since the lowest note
within the four-valved cornet in F section is a F3 (measures 75 to 130), by playing it with
a three-valved Eb cornet, the F3 originally written in the part would be transposed and
1920
converted to a G3 making it possible to be played on a standard three-valved cornet, the
F#3 (concert A3) being the lowest note this instrument could naturally play.
If there is a difficulty being able to find an Eb cornet of any brand then a Eb trumpet
might also be used, but the selection of the mouthpiece could be something deeper than
usual, creating then a more mellow sound and possibly getting closer to a cornet sound. A
good example of a mouthpiece I would try is a combination of a Curry Trumpet-Cornet
(TC) or Trumpet-Flugelhorn (TF) mouthpiece, something in the size that is similar to your
main Bb trumpet mouthpiece. Another example of a mouthpiece I would use is the
Breslmair G3 mouthpiece which offers a deeper cup and I have had very positive
experiences combining it with an Eb trumpet. At a price around $100 it is significantly
cheaper than buying a more or less $4,000 cornet.
Pedagogical Notes
Developing the agility needed to use the pinky finger in the fourth piston in the
trumpet could take time and much practice. Some four-valved trumpets also come with a
support ring for the pinky of the right hand just like regular three-valved instrument,
allowing the trumpeter to use the index finger of the left hand to press down the fourth
piston. Since the flugelhorn is a heavier instrument compared to different keyed trumpets,
it is recommended doing what feels most comfortable for the hands. Using all of the left
hand for the support of the instrument would also help free the right hand to only worry
about the pressing of the pistons. Also, playing slow chromatic scales up and down
involving the fourth piston will improve how natural it feels when the time comes to
2021
perform. In addition, learning all the false fingerings that can be achieved with it will
become very handy in different situations.
It is not very common to have the opportunity to play an F soprano cornet with four
valves, but it is often easier to find and try other instruments keyed near it such as an F/G
trumpet, Eb four-valved and three-valved trumpets. With these instruments, the selection
of the mouthpiece is a critical factor in determining how the instrument responds and how
easy it is to adapt to.
Double tonguing is a common practice for most trumpeters, but in search for a way
to explain double tonging Thomas H. Rollinson is quoted in this document on the
description given in his publication of the Arban’s World Renowned Method for the Cornet
on page 36 (quote below). Also, I advise those seeking technique exercises to improve
upon their double tonging to practice pages 175 and 176 of Goldman’s edition of the
Arbans Complete Celebrated Method for the Cornet (Example 13), as well as creating their
own variations that could suit other similar situations. At measure 113 the oboe and the
solo part trade a beautiful 6 measure melody until the end of the movement.
“The Staccato [tonguing] consists in detaching with regularity, a succession of notes
without allowing the tonguing to be either too short or too long. In order to arrive at this
degree of perfection, studies, which serve as basis, should be very slowly practiced. The
student should first strive to pronounce with perfect equality the syllables: tu-ku; ta-ka.” 15
15
Rollinson
2122
Example 13: Double Tonging Exercises
16
Conga de Flores (Conga of Flowers)
This movement was written for a four-valved D trumpet. it was inspired by Rafael
Mendez, Joseph Haydn, and Frédéric Chopin and it is a monothematic rondo form in E
minor simulating something like a theme and episodes throughout the movement. It also is
the lengthiest, fastest, and perhaps most difficult movement of the piece.
The main theme is an extensive run of sixteenth notes that showcases the virtuosic
fast fingering of the trumpeter, measures 4-21 line (Example 14) The line is then played by
the woodwinds, the xylophone and most strings (Example 15); as the rest of the orchestra
lays the supporting harmonic bed.
16
Goldman
2223
Example 14: Conga de Flores Theme Measure 4
Example 15: Theme on Strings Measure 21
Although most orchestra trumpet parts are not virtuosic or soloistic by nature, is it
vital to continue improving upon all different techniques the instrument might require.
Playing as a soloist, especially a work like Concierto de Otoño will challenge the
trumpeter’s abilities in many different ways. The opening passage of Conga de Flores will
2324
require agility in the fingers, a large variety of articulation and accents as well as
precision/accuracy of the notes.
In measure 38 Márquez introduces the first 4-measure episode that jumps between
the solo line and some woodwinds and strings (Example 19). Although the solo line is fast
and has many notes, this passage offers a very comfortable fingering line when played on
D trumpet. In measure 55 the first episode changes from 4 measures long to 2 measures
long (Example 20) and in measure 63 to 1 measure (Example 21), always tossing the
motive in between the solo and other instruments, making it feel like the end of this section
is very close.
Example 16: First Episode (4 Measures)
//
2425
Example 17: First Episode (2 Measures)
Example 18: First Episode (1 Measure)
2526
In measure 74 there is a new episode introduced, a melodic line in the solo voice
while the strings maintain a very strict regimen of sixteenth notes in a piano dynamic
(Example 22). The line extends until measure 103 where the roles reverse, and the solo
trumpet plays straight sixteenth notes while the melodic line is shared with members of the
woodwind section as well as the string section (Example 23).
In measure 131 the third episode is played by the solo trumpet but was previously
introduced by the congas in the percussion section in measure 71, a 2-measure line that
also includes syncopation, something the performer should be familiar with from the first
movement (Examples 24 – 25).
Example 19: Second Episode
//
2627
Example 20: Second Episode on Strings
Example 21: Conga Introduces Third Episode
Example 22: Third Episode on Trumpet
2728
In measure 159 something very interesting starts happening when the composer
combines material from the third and the first episode but, this time adding more of the
higher register in the solo line (Example 26).
Example 23: Combination of First and Third Episode
Measure 179 marks the return of the theme found in measure 4, a rather extensive
line of sixteenth notes but this time playing through a shorter version of all the episodes
again in preparation to the final cadenza.
There is no cadenza attached to the score or written in the solo line part. For the
premiere Francisco “Pacho” Flores chooses to combine thematic ideas from the previously
seen melodic material as well as extensive use of the range in the trumpet. He even
speaking out loud to thank the public and kissing the mouthpiece to create a louder echo
that comes out of the bell of the trumpet. The cadenza has been changed in sections to
better fit the scenario where the piece is being played. While performing the cadenza in
Colombia with Orquesta Filarmonica de Bogotá, “Pacho” decided to include part of the
national anthem of the Republic of Colombia offering a tribute to the Colombian audience.
2829
The cadenza ends with an octave upwards glissando that marks the coda of the piece
(Example 27). Here the soloist is faced with the highest note in the range of the concerto a
D6 (concert E6), a considerably high note given the fact that the lowest note written in the
score in the second movement is a E3 (concert D3) and a very challenging ending to a piece
that has little rest and a very heavy load of notes to play in all registers.
Example 24: Final Glissando and End of Piece Measure 303
//
Equipment Notes
The concerto was premiered on a Stomvi Titán Eb/D 4 valve edition Trumpet using
its D side by Francisco “Pacho” Flores. Fortunately for trumpeters who are interested in
performing this concerto but might not be able to purchase a four-valved Eb/D instrument,
the movement does not need the fourth piston at all. Instead, regardless of the branding of
the trumpet, conventional three-valved Eb/D trumpets are instruments that nowadays seem
to be part of the majority of trumpeter’s gear since they are commonly used to perform
2930
classical solo repertory written for the instrument and as explained in page 5 of this
document. Using the D side of any of those double keyed trumpets will be fitting to perform
this movement.
Pedagogical Notes
To help the agility and coordination needed in Conga de Flores there are many
exercises that will improve upon these needs, but here are a few recommendations for those
reading this essay.
• Clarke’s Technical Studies for The Cornet “Second Study” on page 8
(Example 16), a download link to the public domain version used in this
essay is available in footnote 17 as well as the bibliography of this
document.
• Goldman’s version of Arban’s Complete Celebrated Method for the Cornet
"Exercises on Sixteenth Notes” on page 137 (Example 17) as well as its
“Preparatory Exercises on The Grupetto” on page 91 (Example 18).
After being familiar with the above-mentioned exercises, it is recommended to
work on the solo part at a slower tempo than marked in the part, getting used to the
harmonic sequences and increasing the tempo as it becomes more comfortable. If the player
starts to feel exhaustion from the practicing, then a good trick is to mock the air with the
articulation without putting the trumpet in the lips but continue to use the pistons of the
trumpet to improve the coordination of the fingers.
For the sixteenth notes on the trumpet solo part, the most comfortable way to play
this line will be using double tonguing, unless the tempo is slow enough for it to be clear
3031
and not fall behind tempo with single tonguing. Exercises on example 13 and pages 173 –
182 of Goldman’s version of the Arban’s Complete Celebrated Method for the Cornet will
help improving the multiple tonguing and fast fingerings with articulations.
Accuracy could be very challenging during the preparation of these passages and
even more when there is not time to rest the embouchure for the different registers. The
player should setup in the mouthpiece as they were to play a concert G4 in the first measure
and it should help you with the preparation for the sections as well as being able to mentally
sing the melody line and being conscious about all of the challenging changes of register.
Example 25: Recommended Agility Clarke Exercises
17
17
Clarke, Herbert H. Clarke's Technical Studies for The Cornet. Indiana, Indianapolis: L. B. Clarke
Elkhardt, 1912. Copyright Public Domain
https://imslp.org/wiki/Clarke%27s_Technical_Studies_for_the_Cornet_(Clarke%2C_Herbert_Lincoln)
3132
Example 26: Recommended Arban Agility Exercise No. 1
18
18
Goldman
3233
Example 27: Recommended Arban Agility Exercise No. 2
19
20
19
Goldman
20
Goldman
3334
Chapter 3
Francisco “Pacho” Flores Biography
Francisco “Pacho” Flores was born in 1981 in San Cristóbal, Venezuela. He was
eight when he began studying with his father, Francisco Flores Díaz, a trumpeter and band
director who told him: “Pachito, you have good lips. You will be a trumpeter.” A product
of Venezuela’s groundbreaking system of youth and children’s orchestras (El Sistema), he
later studied with Orlando Paredes at the Escuela de Música Miguel Ángel Espinel,
Eduardo Manzanilla at the Instituto Universitario de Estudios Musicales in Caracas and
with Eric Aubier in Paris, where in 2005 he earned a conservatory diploma with an
unanimously awarded Prix de Virtuosité. He has won no fewer than four international
competitions including the 2006 Maurice Andre Trumpet Competition in Paris.21
In 2012 “Pacho” Flores became an exclusive Deutsche Grammophon artist. “Pacho
plays the trumpet the way a singer uses his voice. The music Pacho makes is like that of a
soul expressing itself.” Says Rolando Villazón, the tenor with whom he recorded one of
his CDs “Adiemus Colores” an album of new Latin American-influenced compositions by
Karl Jenkins under this label. In 2009 he recorded his first CD under the Jazz category
called “La Trompeta Venezolana” (The Venezuelan Trumpet). His first classical recording,
"Cantar", was released internationally in 2014, with an initial pre-release in Japan in 2013.
On this album, he performs on nine instruments in different keys from his large collection,
choosing the ideal one for each work in a largely Baroque program. The one non-baroque
21
Rupert Wagg, “Pacho Flores | Biography,” www.deutschegrammophon.com, January 1, 2018,
https://www.deutschegrammophon.com/en/artists/pacho-flores/biography.
3435
piece on the album is a new work called, “Soledad” (Solitude). It was composed for Flores
by Efraín Oscher and showcases the exceptional range and beauty of his tone and phrasing.
Pacho says: “Not all of the works are originally for trumpet. They are for other instruments:
violin, oboe, guitar, piano, organ, soprano or contralto. Each piece is recorded with a
different trumpet that gives a distinct nuance, a different colour.” 22
Flores’ large collection of different keyed instruments results from his partnership
with Stomvi instruments from Spain. Pacho has been able to develop a new revolutionary
idea of every trumpet having four instead of three pistons. It has long been common for
piccolo trumpets to have 4 valves, and in recent years some the flugelhorns have come to
market that include a fourth valve as well. However, it is very rare to see other trumpets
feature the use of a fourth valve. The purpose of the fourth piston is to allow the trumpeter
to reach five semitones lower and turning the pedal notes to actual playing notes in the
instrument. Pacho prefers to use a four-valve system trumpet to be able to expand the
number of pieces in his repertory by doing transcriptions or simply by playing pieces
composed for other instruments and only having to change very little such as a few octaves
here and there. Variations on a Rococo Theme by Pyotr Ilyich Tchaikovsky originally
written for cello, is an example of a piece that could be done on a four-piston flugelhorn.
Added to that, the combination of uncommonly seen keyed trumpets like the F four-piston
soprano cornet, Eb four-piston trumpet, and corno di caccia allows Flores to obtain
different colors with the instrument, all of which are tailored by Stomvi to his preferences
and requirements.
22
Pacho Flores, “Pacho Flores, Konzerthausorchester Berlin, Ralf Benesch, Martin Kistner, Christian
Badzura, Hansjörg Seiler, Philipp Nedel – Cantar (2013) High-Fidelity FLAC Stereo 24bit/96kHz,”
FLAC.st, October 9, 2018, https://rickdog-classical.rssing.com/chan-69767830/all_p889.html
3536
As a soloist, Flores has appeared with orchestras in France, Russia, Ukraine, USA,
Latin America and Japan, as well as with the Simón Bolívar Symphony Orchestra. In
recital, he has performed at such venues as Carnegie Hall in New York, the Salle Pleyel in
Paris and the Tokyo Opera City Concert Hall. With the Simón Bolívar Brass Quintet, he
has toured extensively in Europe, South America, the US and Japan. In addition to his post
in the Simón Bolívar Symphony Orchestra, he has played first trumpet in the Saito Kinen
and Miami Symphony orchestras and has performed under the baton of such distinguished
conductors as Claudio Abbado, Sir Simon Rattle, Seiji Ozawa, Giuseppe Sinopoli, Rafael
Frühbeck de Burgos and Gustavo Dudamel.23
Flores has been a leading force in the commission of new works by Latin American
composers and expanding the recorded repertory of the trumpet with many adaptations to
the instrument. Also, his many recitals and concerts around the globe have exploded the
exposure of trumpet in Latin American music, also encouraging many more like myself to
perform pieces from our native countries (Venezuela and Colombia) more often as well as
exploring the richness of folk and traditional music from other regions.
23
Carrie Jones, “Pacho Flores, Trumpet,” San Diego Symphony, March 25, 2019,
https://www.sandiegosymphony.org/about-the-sdso/artistic/guest-artists/member/pacho-flores-trumpet/.
3637
Chapter 4
Conclusion
Looking towards the future, it will always be very important to not overlook
works for our own instrument simply because it is not part of the mainstream of pieces
played by most people. I believe pieces like Concierto de Otoño offer an incredible range
of colors, textures, and melodies that will challenge professionals for its performance. The
only way to expand the repertory of an instrument such as the trumpet is to commission
and perform new pieces. This will also ensure the continuous development of our
instrument. As a trumpet player myself, I look forward to joining the groups of people who
challenge traditional mainstream pieces and work on ways to program different music
during their recitals and concerts, furthering a multi-cultured musical world.
Future work on this piece for me will involve programming it when possible and
not only playing Latin American music in Latin America but all around the world. My
hope is to encourage many others to reach out to composers and start working on new
pieces so that everyone contributes their little bit towards it. I have been inspired by my
professor during this time as a student to learn so much more about what is beyond the
trumpet itself and explore the many faces it might have.
For those who might be interested in performing Concierto de Otoño in the future
I cannot tell you how much joy I have had putting together this guide for you. A piece full
of very difficult but fun music that will light up the room in where it might be played.
3738
Bibliography
Americas, Orchestra. “Arturo Márquez – The Orchestra of the Americas.”
Orchestra of the Americas, March 23, 2006. http://oamericas.org/people/arturo-marquez-
2/
Bárzana García, Eduardo. “Orquesta Filarmónica de La UNAM.”
www.amigosofunam.unam.mx. Accessed November 12, 2020.
http://www.amigosofunam.unam.mx
Clarke, Herbert H. Clarke's Technical Studies for The Cornet. Indiana,
Indianapolis: L. B. Clarke Elkhardt, 1912.
https://imslp.org/wiki/Clarke%27s_Technical_Studies_for_the_Cornet_(Clarke%2C_Her
bert_Lincoln)
Flores, Pacho. “Pacho Flores, Konzerthausorchester Berlin, Ralf Benesch, Martin
Kistner, Christian Badzura, Hansjörg Seiler, Philipp Nedel – Cantar (2013) High-Fidelity
FLAC Stereo 24bit/96kHz.” FLAC.st, October 9, 2018. https://rickdog-
classical.rssing.com/chan-69767830/all_p889.html
Goldman, Edwin Franko. Arban’s Complete Celebrated Method for the Cornet.
New York: Carl Fischer, 1893. Plate 3654. Copyright Public Domain.
https://imslp.org/wiki/Method_for_the_Cornet_(Arban%2C_Jean-Baptiste)
Jones, Carrie. “Pacho Flores, Trumpet.” San Diego Symphony, March 25, 2019.
https://www.sandiegosymphony.org/about-the-sdso/artistic/guest-artists/member/pacho-
flores-trumpet/.
Magan, Carlos. “ACM Concerts, Autor En ACM Concerts - Page 5 of 11.” ACM
Concerts. ACM Concerts. Accessed March 1, 2021.
https://acmconcerts.com/en/author/carlos-magan/page/5/.
Marquez, Arturo. Concierto De Otoño Para Trompeta y Orquesta. Valencia:
Particella Ediciones, 2018.
Marquez, Arturo. “Amante de La Musica Mariachi Del Parrandon Vallenato.”
Arturo Marquez “El Gran Compositor,” October 13, 2019.
http://www.arturomarquez.org.
Merriam-Webster.com Dictionary, s.v. “floripondio,” accessed March 11, 2021,
https://www.merriam-webster.com/dictionary/floripondio.
Orquesta Filarmónica de Bogotá, and Orquestafilarmonicadebogota. “Programa
De Mano Octubre y Noviembre 2019 Orquesta Filarmónica De Bogotá.” Issuu, October
3839
1, 2019.
https://issuu.com/orquestafilarmonicadebogota/docs/programa_de_mano_octubre_-
_noviembre.
“Predeterminado Del Sitio.” Info del NEA, August 11, 2020.
https://infodelnea.com.ar/wp/2020/08/11/las-plantas-venenosas-a-tener-cuidado/.
Prieto, Carlos Miguel. “Carlos Miguel Prieto.” www.carlosmiguelprieto.com.
Accessed November 12, 2020. http://www.carlosmiguelprieto.com/en/.
Rollinson, Thomas H. Arbans World Renowned Method for the Cornet.
Philadelphia, PA: J. W. Pepper, 1879. Public Domain
https://imslp.org/wiki/Method_for_the_Cornet_(Arban%2C_Jean-Baptiste)
Trumpets, Stomvi. “Pacho Flores Premieres Arturo Márquez’s Trumpet Concerto
| Pacho Flores.” pachoflores.com. Accessed November 12, 2020.
https://pachoflores.com/en/news-en/pacho-flores-premieres-arturo-marquezs-trumpet-
concerto.
Wagg, Rupert. “Pacho Flores | Biography.” www.deutschegrammophon.com,
January 1, 2018. https://www.deutschegrammophon.com/en/artists/pacho-
flores/biography.
3940
Appendix A
Copyright Watermark on Score with Using Rights for this Document
4041
Appendix B
Keynote Presentation Slides for Lecture Recital.
4142 42
43 43
44 44
45 45
46 46
47 47
48 48
49 49
50 50
51 51
You can also read